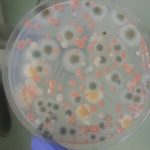
NASA Uluslararası Uzay İstasyonu’ndaki Mikropları İnceliyor

Ana Sayfa Ara
evrim - arama sonuçları
Aradığını bulamadıysan, yeni bir arama yap
NASA Uluslararası Uzay İstasyonu’ndaki Mikropları İnceliyor
Yakında Uluslarası Uzay İstasyonu’nda mikroplar üzerine bir çalışma alanı kurulabilir. NASA, 21 Eylül'de uzay istasyonunu ziyaret etmiş 200’den fazla astronotun beraberinde götürdüğü ufak canlıları...
2016’da Keşfedilen Fosillerden Favoriniz Olanı Oylayabilirsiniz!
Bu yıl kaç yeni türün fosilleri keşfedildi? Favorilerinizi oylayabilecek kadar çok.
Akademik dergi PLOS One, bu sıralar okuyucuları için oylama etkinliğine ev sahipliği yapıyor, böylelikle...
Elon Musk’ın Bizi Mars’a Götürecek Çılgın Planları
Elon Musk büyük ihtimalle ‘her gün yapılacaklar listesine’; enerji, ulaşım ve uzay yolculuğunda devrim yaratan şirketlerini yürütmenin yanında “dünyayı kurtarmak” da yazıyordur. Önümüzdeki 10...
Koni Salyangozu’nun Zehri, Hızlı-Etkili Diyabet Tedavileri İçin Kullanılabilir!
Avustralya ve Amerikalı bilim insanları, koni salyangozlarının avlarını sersemletmek için salgıladığı insülinin yapısını çözdüler. Bu deniz salyangozunun zehrinin nasıl bu kadar hızlı yayıldığının anlaşılması,...
Hamamböceği Makaleleri: Bilinenleri ve Tarihi ile İlgili Bir İnceleme
Yazar Richard Schweid, gerçekten yaşanmış korktucu bir deneyim ile bilim ve bilim kurguyu birleştirerek hayatta kalma başarısı konusunda birinci, çöp yiyicilerini, yani hamamböceklerini kitabında...